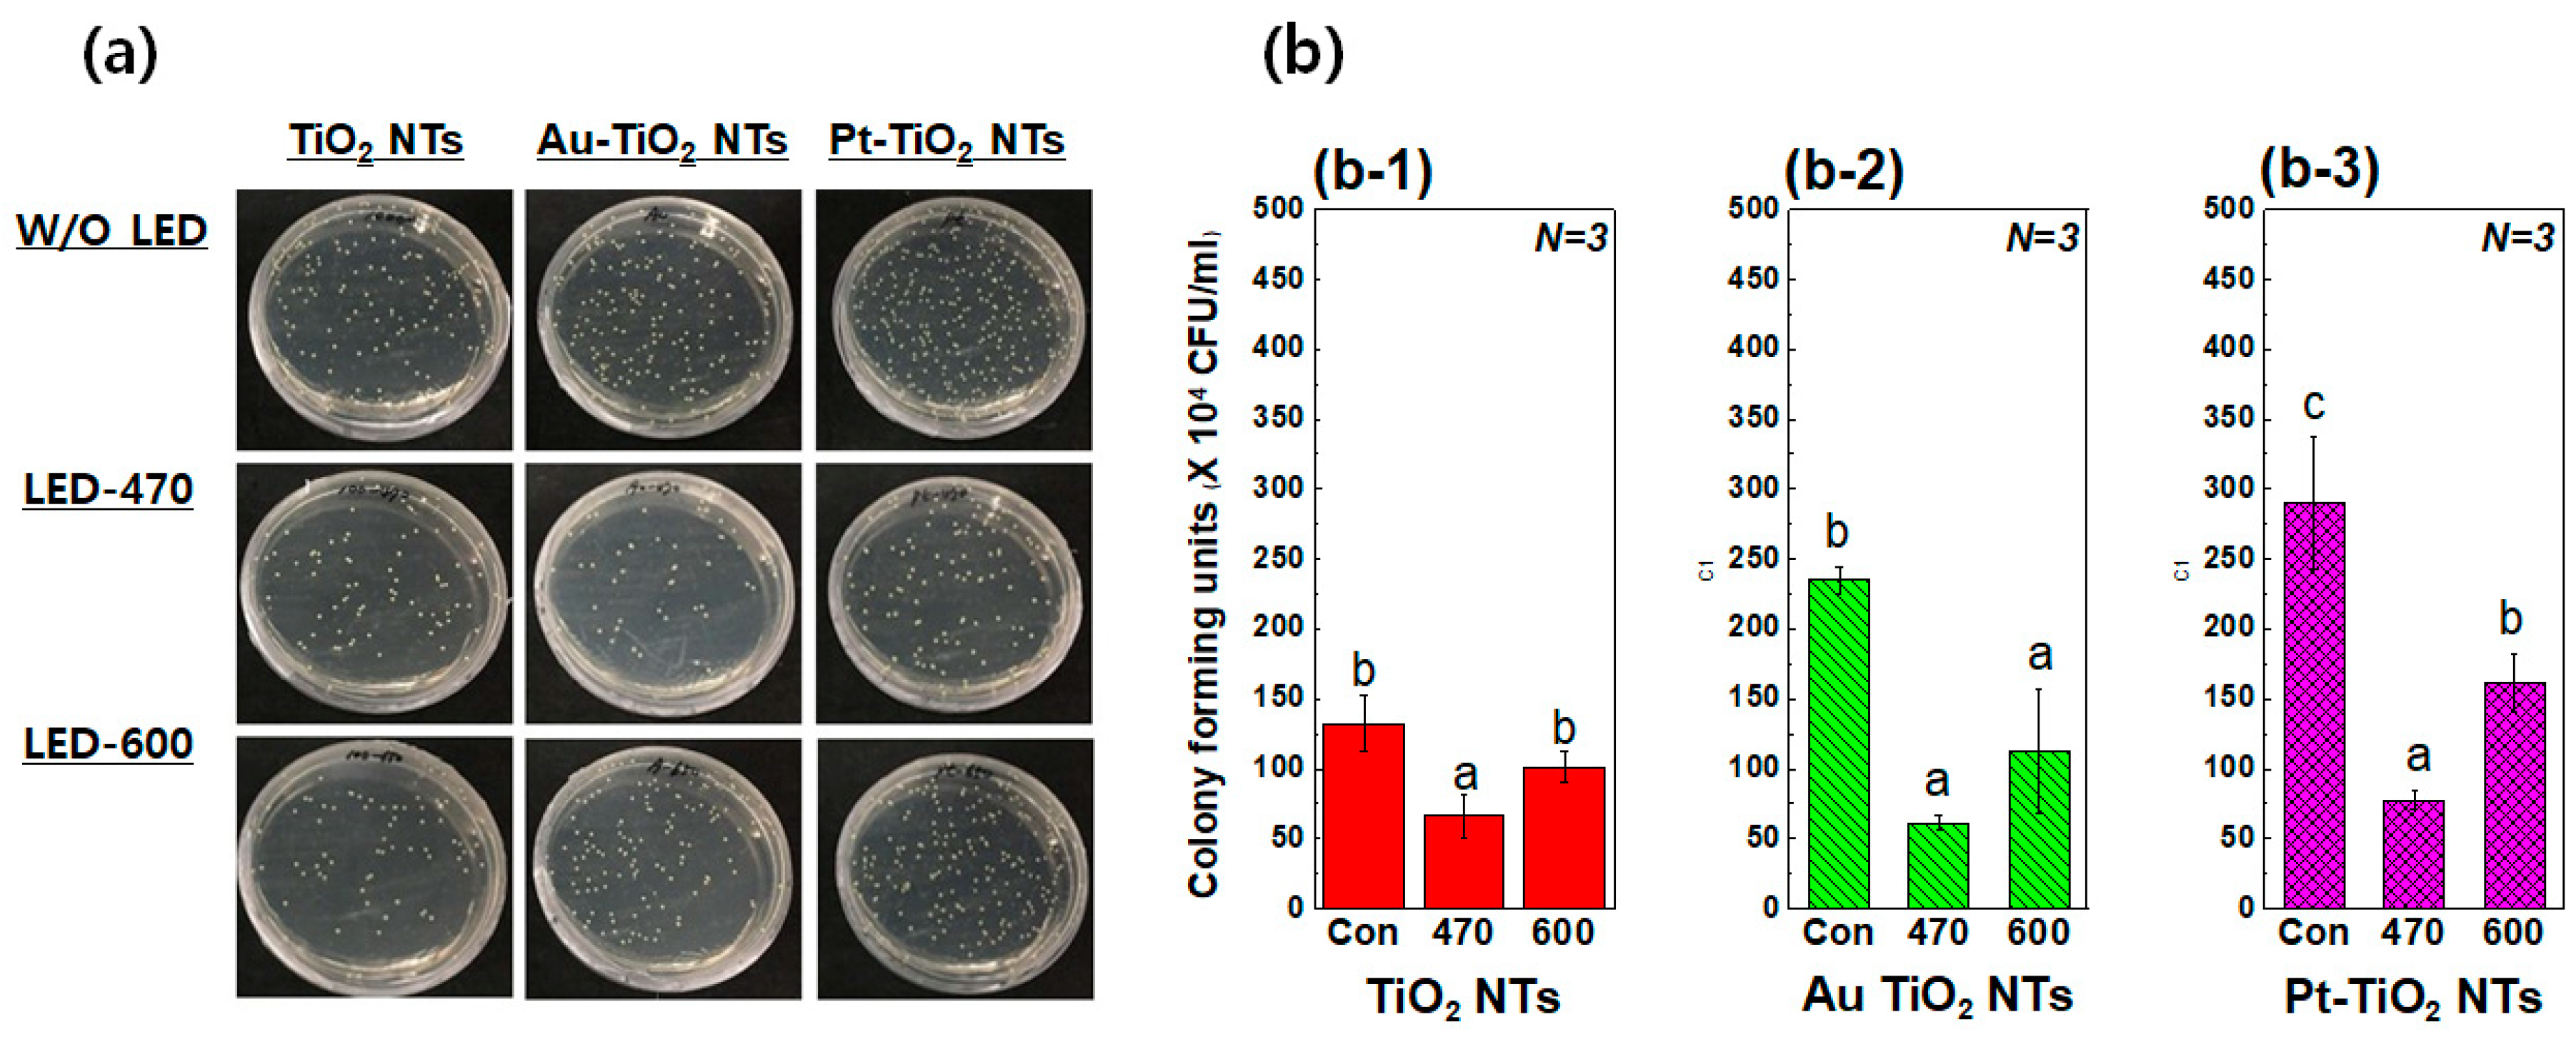
Materials 13 03721 g005

Visible Light-Enhanced Antibacterial and Osteogenic Functionality of Au and Pt Nanoparticles Deposited on TiO2 Nanotubes
Abstract
1. Introduction
2. Materials and Methods
2.1. Materials Preparation of Au–TiO2 NTs and Pt–TiO2 Nanotubes
2.2. Surface Characterization
2.3. Antibacterial Activity Test
2.4. The Culture of Human Mesenchymal Stem Cells
2.5. Calcein AM/EthD-1 Staining of hMSCs and MTT Cell Viability Assay
2.6. Morphological Evaluation of hMSCs with Visible Light Irradiation
2.7. Alkaline Phosphatase (ALP) Activity Assay
2.8. Quantitative Real-Time PCR Assay
2.9. Data Analysis
3. Results
3.1. Suface Characteristics
3.1.1. Field Emission Scanning Electron Microscope (FE-SEM)
3.1.2. Diffuse UV-Vis-NIR Spectroscopy
3.1.3. Transmission Electron Microscope (TEM)
3.1.4. X-ray Photoelectron Spectroscopy (XPS)
3.2. Antibacterial Agar Diffusion Test with Visible Light Irradiation
3.3. Biocompatibilty and Ostegenic Functionality Tests with Visible Light Irradiation
3.3.1. Live/Dead Assay and MTT Assay
3.3.2. Micro Observation of hMSCs Morphology by FE-SEM
3.3.3. Alkaline Phosphatase Activity Assay
3.3.4. Quantitative Real-Time PCR Assay
4. Discussion
5. Conclusions
Author Contributions
Funding
Conflicts of Interest
References
- Karthik, K.; Sivakumar, S.; Thangaswamy, V. Evaluation of implant success: A review of past and present concepts. J. Pharm. Bioall. Sci. 2013, 5, S117–S119. [Google Scholar] [CrossRef]
- Porter, J.A.; von Fraunhofer, J.A. Success or failure of dental implants? A literature review with treatment considerations. Gen. Dent. 2005, 53, 423–432. [Google Scholar]
- Snauwaert, K.; Duyck, J.; van Steenberghe, D.; Quirynen, M.; Naert, I. Time dependent failure rate and marginal bone loss of implant supported prostheses: A 15-year follow-up study. Clin. Oral Investig. 2000, 4, 13–20. [Google Scholar] [CrossRef]
- Park, J.H.; Olivares-Navarrete, R.; Baier, R.E.; Meyer, A.E.; Tannenbaum, R.; Boyan, B.D.; Schwartz, Z. Effect of cleaning and sterilization on titanium implant surface properties and cellular response. Acta Biomater. 2012, 8, 1966–1975. [Google Scholar] [CrossRef]
- Gursel, I.; Korkusuz, F.; Turesin, F.; Alaeddinoglu, N.G.; Hasirci, V. In vivo application of biodegradable controlled antibiotic release systems for the treatment of implant-related osteomyelitis. Biomaterials 2001, 22, 73–80. [Google Scholar] [CrossRef]
- Geuli, O.; Metoki, N.; Zada, T.; Reches, M.; Eliaz, N.; Mandler, D. Synthesis, coating, and drug-release of hydroxyapatite nanoparticles loaded with antibiotics. J. Mater. Chem. B 2017, 5, 7819–7830. [Google Scholar] [CrossRef]
- Hsu, Y.H.; Chen, D.W.; Tai, C.D.; Chou, Y.C.; Liu, S.J.; Ueng, S.W.; Chan, E.C. Biodegradable drug-eluting nanofiber-enveloped implants for sustained release of high bactericidal concentrations of vancomycin and ceftazidime: In vitro and in vivo studies. Int. J. Nanomed. 2014, 9, 4347–4355. [Google Scholar] [CrossRef] [PubMed]
- Kenawyel, R.; Worley, S.D.; Broughton, R. The chemistry and applications of antimicrobial polymers: A state-of-the-art review. Biomacromolecules 2007, 8, 1359–1384. [Google Scholar] [CrossRef] [PubMed]
- Cheon, J.Y.; Kim, S.J.; Rhee, Y.H.; Kwon, O.H.; Park, W.H. Shape-dependent antimicrobial activities of silver nanoparticles. Int. J. Nanomed. 2019, 14, 2773–2780. [Google Scholar] [CrossRef] [PubMed]
- Tang, S.; Zheng, J. Antibacterial activity of silver nanoparticles: Structural effects. Adv. Healthc. Mater. 2018, 7, 1–10. [Google Scholar] [CrossRef]
- Rajesh, S.; Koshi, E.; Philip, K.; Mohan, A. Antimicrobial photodynamic therapy: An overview. J. Indian Soc. Periodontol. 2011, 15, 323–327. [Google Scholar] [PubMed]
- Nagay, B.E.; Dini, C.; Cordeiro, J.M.; Ricomini-Filho, A.P.; de Avila, E.D.; Rangel, E.C.; da Cruz, N.C.; Barao, V.A.R. Visible-light-induced photocatalytic and antibacterial activity of TiO2 codoped with nitrogen and bismuth: New perspectives to control implant-biofilm-related Diseases. ACS Appl. Mater. Interfaces 2019, 11, 18186–18202. [Google Scholar] [CrossRef] [PubMed]
- Carre, G.; Hamon, E.; Ennahar, S.; Estner, M.; Lett, M.C.; Horvatovich, P.; Gies, J.P.; Keller, V.; Keller, N.; Andre, P. TiO2 photocatalysis damages lipids and proteins in Escherichia coli. Appl. Environ. Microbiol. 2014, 80, 2573–2581. [Google Scholar] [CrossRef] [PubMed]
- Gyorgyey, A.; Janovak, L.; Adam, A.; Kopniczky, J.; Toth, K.L.; Deak, A.; Panayotov, I.; Cuisinier, F.; Dekany, I.; Turzo, K. Investigation of the in vitro photocatalytic antibacterial activity of nanocrystalline TiO2 and coupled TiO2/Ag containing copolymer on the surface of medical grade titanium. J. Biomater. Appl. 2016, 31, 55–67. [Google Scholar] [CrossRef] [PubMed]
- Xia, S.M.; Zhang, Y.Q.; Zheng, Y.F.; Xu, C.S.; Liu, G.M. Enhanced visible light photocatalytic activity of N, F-codoped TiO2 powders with high thermal stability. Environ. Technol. 2019, 40, 1418–1424. [Google Scholar] [CrossRef]
- Ali, I.; Kim, J.O. Visible-light-assisted photocatalytic activity of bismuth-TiO2 nanotube composites for chromium reduction and dye degradation. Chemosphere 2018, 207, 285–292. [Google Scholar] [CrossRef]
- Fu, A.; Chen, X.; Tong, L.; Wang, D.; Liu, L.; Ye, J. Remarkable Visible-Light Photocatalytic Activity Enhancement over Au/p-type TiO2 Promoted by Efficient Interfacial Charge Transfer. ACS Appl. Mater. Interfaces 2019, 11, 24154–24163. [Google Scholar] [CrossRef]
- Qin, L.; Wang, G.; Tan, Y. Plasmonic Pt nanoparticles-TiO2 hierarchical nano-architecture as a visible light photocatalyst for water splitting. Sci. Rep. 2018, 8, 16198. [Google Scholar] [CrossRef]
- Dong, F.; Wang, H.; Sen, G.; Wu, Z.; Lee, S.C. Enhanced visible light photocatalytic activity of novel Pt/C-doped TiO2/PtCl4 three-component nanojunction system for degradation of toluene in air. J. Hazard. Mater. 2011, 187, 509–516. [Google Scholar] [CrossRef]
- Sun, H.; He, Q.; She, P.; Zeng, S.; Xu, K.; Li, J.; Liang, S.; Liu, Z. One-pot synthesis of Au@TiO2 yolk-shell nanoparticles with enhanced photocatalytic activity under visible light. J. Colloid. Interf. Sci. 2017, 505, 884–891. [Google Scholar] [CrossRef]
- Ueda, T.; Ueda, K.; Ito, K.; Ogasawara, K.; Kanetaka, H.; Mokudai, T.; Niwano, Y.; Narushima, T. Visible-light-responsive antibacterial activity of Au-incorporated TiO2 layers formed on Ti–(0–10)at%Au alloys by air oxidation. J. Biomed. Mater. Res. A 2019, 107, 991–1000. [Google Scholar] [CrossRef]
- Hul, Y.; Donq, F.; Liu, H.; Guo, X. Influence of Pt and Pd modification on the visible light photocatalytic activity of N-doped titania photocatalysts. J. Nanosci. Nanotechnol. 2016, 16, 3570–3576. [Google Scholar] [PubMed]
- Moon, K.S.; Bae, J.M.; Jin, S.; Oh, S. Infrared-mediated drug elution activity of gold nanorod-grafted TiO2 Nanotubes. J. Nanomater. 2014, 750813, 1–8. [Google Scholar]
- Moon, K.S.; Park, Y.B.; Bae, J.M.; Oh, S. Near-infrared laser-mediated drug release and antibacterial activity of gold nanorod–sputtered titania nanotubes. J. Tissue Eng. 2018, 9, 1–9. [Google Scholar] [CrossRef] [PubMed]
- Li, J.; Zhou, H.; Qian, S.; Liu, Z.; Feng, J.; Jin, P.; Liu, X. Plasmonic gold nanoparticles modified titania nanotubes for antibacterial application. Appl. Phys. Lett. 2014, 104, 1–5. [Google Scholar] [CrossRef]
- Li, Q.; Li, Y.W.; Liu, Z.; Xie, R.; Shang, J.K. Memory antibacterial effect from photoelectron transfer between nanoparticles and visible light photocatalyst. J. Mater. Chem. 2010, 20, 1068–1072. [Google Scholar] [CrossRef]
- Wang, G.; Feng, H.; Gao, A.; Chu, P. Bacterial Inactivation Mechanism of Titania Nanotubes Modified with Gold Nanoparticles. In Proceedings of the 10th World Biomaterials Congress, Montreal, QC, Canada, 17–22 May 2016; Frontiers in Bioengineering and Biotechnology: Montreal, QC, Canada, 2016. [Google Scholar]
- ISO 10993–5 Biological Evaluation of Medical Devices—Part 5: Tests for In Vitro Cytotoxicity; ISO: Geneva, Switzerland, 2009.
- Chen, Y.S.; Frey, W.; Kim, S.; Homan, K.; Kruizinga, P.; Sokolov, K.; Emelianov, S. Enhanced thermal stability of silica-coated gold nanorods for photoacoustic imaging and image-guided therapy. Opt. Express. 2010, 18, 8867–8878. [Google Scholar] [CrossRef]
- ISO 7405 Dentistry—Evaluation of Biocompatibility of Medical Devices Used in Dentistry; ISO: Geneva, Switzerland, 2018.
- Henderson, M.A. A surface science perspective on TiO2 photocatalysis. Surf. Sci. Rep. 2011, 66, 185–297. [Google Scholar] [CrossRef]
- Miron, R.J.; Zhang, Y.F. Osteoinduction: A review of old concepts with new standards. J. Dent. Res. 2012, 91, 736–744. [Google Scholar] [CrossRef]
- Tang, Z.; Li, X.; Tan, Y.; Fan, H.; Zhang, X. The material and biological characteristics of osteoinductive calcium phosphate ceramics. Regen. Biomater. 2018, 5, 43–59. [Google Scholar] [CrossRef]
- Gu, D.; Wang, Y.; Li, Z.D.; Liu, Y.; Wang, B.H.; Wu, H.J. UV-light aided photoelectrochemical synthesis of Au/TiO2 NTs for photoelectrocatalytic degradation of HPAM. RSC Adv. 2016, 6, 63711–63716. [Google Scholar] [CrossRef]
- Fang-Xing, X.; Hung, S.F.; Miao, J.W.; Wang, H.Y.; Yang, H.B.; Liu, B. Metal-Cluster-Decorated TiO2 Nanotube Arrays: A Composite Heterostructure toward Versatile Photocatalytic and Photoelectrochemical Applications. Small 2015, 11, 554–567. [Google Scholar]
- Yoo, S.M.; Rawal, S.B.; Lee, J.E.; Kim, J.; Ryu, H.Y.; Park, D.W.; Lee, W.I. Size-dependence of plasmonic Au nanoparticles in photocatalytic behavior of Au/TiO2 and Au@SiO2/TiO2. Appl. Catal. A Gen. 2015, 499, 47–54. [Google Scholar] [CrossRef]
- Lin, Z.J.; Wang, X.H.; Liu, J.; Tian, Z.Y.; Dai, L.C.; He, B.B.; Han, C.; Wu, Y.G.; Zeng, Z.G.; Hu, Z.Y. On the role of localized surface plasmon resonance in UV-Vis light irradiated Au/TiO2 photocatalysis systems: Pros and cons. Nanoscale 2015, 7, 4114–4123. [Google Scholar] [CrossRef] [PubMed]
- Khlebtsov, B.N.; Khlebtsov, N.G. Multipole plasmons in metal nanorods: Scaling properties and dependence on particle size, shape, orientation, and dielectric environment. J. Phys. Chem. C 2007, 111, 11516–11527. [Google Scholar] [CrossRef]
- Liao, Q.; Mu, C.; Xu, D.S.; Ai, X.C.; Yao, J.N.; Zhang, J.P. Gold Nanorod Arrays with Good Reproducibility for High-Performance Surface-Enhanced Raman Scattering. Langmuir 2009, 25, 4708–4714. [Google Scholar] [CrossRef] [PubMed]
- Zhang, K.; Xiang, Y.J.; Wu, X.C.; Feng, L.L.; He, W.W.; Liu, J.B.; Zhou, W.Y.; Xie, S.S. Enhanced Optical Responses of Au@Pd Core/Shell Nanobars. Langmuir 2009, 25, 1162–1168. [Google Scholar] [CrossRef]
- Nagasawa, Y.; Choso, T.; Karasuda, T.; Shimomura, S.; Ouyang, F.; Tabata, K.; Yamaguchi, Y. Photoemission study of the interaction of a reduced thin film SnO2 with oxygen. Surf. Sci. 1999, 433, 226–229. [Google Scholar] [CrossRef]
- Vuong, N.M.; Kim, D.; Kim, H. Porous Au-embedded WO3 Nanowire Structure for Efficient Detection of CH4 and H2S. Sci. Rep. 2015, 5, 11040. [Google Scholar]
- Sutherland, J.C. Biological effects of polychromatic light. Photochem. Photobiol. 2002, 76, 164–170. [Google Scholar] [CrossRef]
- Kim, W.S.; Calderhead, R.G. Is light-emitting diode phototherapy (LED-LLLT) really effective? Laser Ther. 2011, 20, 205–215. [Google Scholar] [CrossRef] [PubMed]
- Hopkins, J.T.; McLoda, T.A.; Seegmiller, J.G.; David Baxter, G. Low-Level Laser Therapy Facilitates Superficial Wound Healing in Humans: A Triple-Blind, Sham-Controlled Study. J. Athl. Train. 2004, 39, 223–229. [Google Scholar] [PubMed]
- Aimbire, F.; Albertini, R.; Pacheco, M.T.; Castro-Faria-Neto, H.C.; Leonardo, P.S.; Iversen, V.V.; Lopes-Martins, R.A.; Bjordal, J.M. Low-level laser therapy induces dose-dependent reduction of TNFalpha levels in acute inflammation. Photomed. Laser. Surg. 2006, 24, 33–37. [Google Scholar] [CrossRef] [PubMed]
- Briguglio, F.; Falcomata, D.; Marconcini, S.; Fiorillo, L.; Briguglio, R.; Farronato, D. The Use of Titanium Mesh in Guided Bone Regeneration: A Systematic Review. Int. J. Dent. 2019, 2019, 9065423. [Google Scholar] [CrossRef]
- Deguchi, T.; Takano-Yamamoto, T.; Kanomi, R.; Hartsfield, J.K., Jr.; Roberts, W.E.; Garetto, L.P. The use of small titanium screws for orthodontic anchorage. J. Dent. Res. 2003, 82, 377–381. [Google Scholar] [CrossRef]
- Stasio, D.D.; Lauritano, D.; Iquebal, H.; Romano, A.; Gentile, E.; Lucchese, A. Measurement of Oral Epithelial Thickness by Optical Coherence Tomography. Diagnostics (Basel) 2019, 9, 90. [Google Scholar] [CrossRef]
- Avci, P.; Gupta, A.; Sadasivam, M.; Vecchio, D.; Pam, Z.; Pam, N.; Hamblin, M.R. Low-level laser (light) therapy (LLLT) in skin: Stimulating, healing, restoring. Semin. Cutan. Med. Surg. 2013, 32, 41–52. [Google Scholar]
- Rakhmatia, Y.D.; Ayukawa, Y.; Furuhashi, A.; Koyano, K. Current barrier membranes: Titanium mesh and other membranes for guided bone regeneration in dental applications. J. Prosthodont. Res. 2013, 57, 3–14. [Google Scholar] [CrossRef]

| Metal Target | Sputtering Time (min) | Diameter (nm) | Height (nm) | Aspect Ratio |
|---|---|---|---|---|
| Au | 1 | 9.36 ± 1.88 | 8.77 ± 1.90 | 1:0.94 |
| 2 | 13.05 ± 2.22 | 11.79 ± 2.41 | 1:0.90 | |
| 3 | 18.29 ± 6.44 | 30.77 ± 3.28 | 1:1.68 | |
| Pt | 1 | 15.35 ± 4.31 | 18.65 ± 3.75 | 1:1.22 |
| 2 | 20.72 ± 5.21 | 30.42 ± 6.01 | 1:1.47 | |
| 3 | 24.23 ± 4.40 | 48.24 ± 6.41 | 1:1.99 |
© 2020 by the authors. Licensee MDPI, Basel, Switzerland. This article is an open access article distributed under the terms and conditions of the Creative Commons Attribution (CC BY) license (http://creativecommons.org/licenses/by/4.0/).
Share and Cite
Moon, K.-S.; Choi, E.-J.; Bae, J.-M.; Park, Y.-B.; Oh, S. Visible Light-Enhanced Antibacterial and Osteogenic Functionality of Au and Pt Nanoparticles Deposited on TiO2 Nanotubes. Materials 2020, 13, 3721. https://doi.org/10.3390/ma13173721
Moon K-S, Choi E-J, Bae J-M, Park Y-B, Oh S. Visible Light-Enhanced Antibacterial and Osteogenic Functionality of Au and Pt Nanoparticles Deposited on TiO2 Nanotubes. Materials. 2020; 13(17):3721. https://doi.org/10.3390/ma13173721
Chicago/Turabian StyleMoon, Kyoung-Suk, Eun-Joo Choi, Ji-Myung Bae, Young-Bum Park, and Seunghan Oh. 2020. "Visible Light-Enhanced Antibacterial and Osteogenic Functionality of Au and Pt Nanoparticles Deposited on TiO2 Nanotubes" Materials 13, no. 17: 3721. https://doi.org/10.3390/ma13173721
APA StyleMoon, K.-S., Choi, E.-J., Bae, J.-M., Park, Y.-B., & Oh, S. (2020). Visible Light-Enhanced Antibacterial and Osteogenic Functionality of Au and Pt Nanoparticles Deposited on TiO2 Nanotubes. Materials, 13(17), 3721. https://doi.org/10.3390/ma13173721

